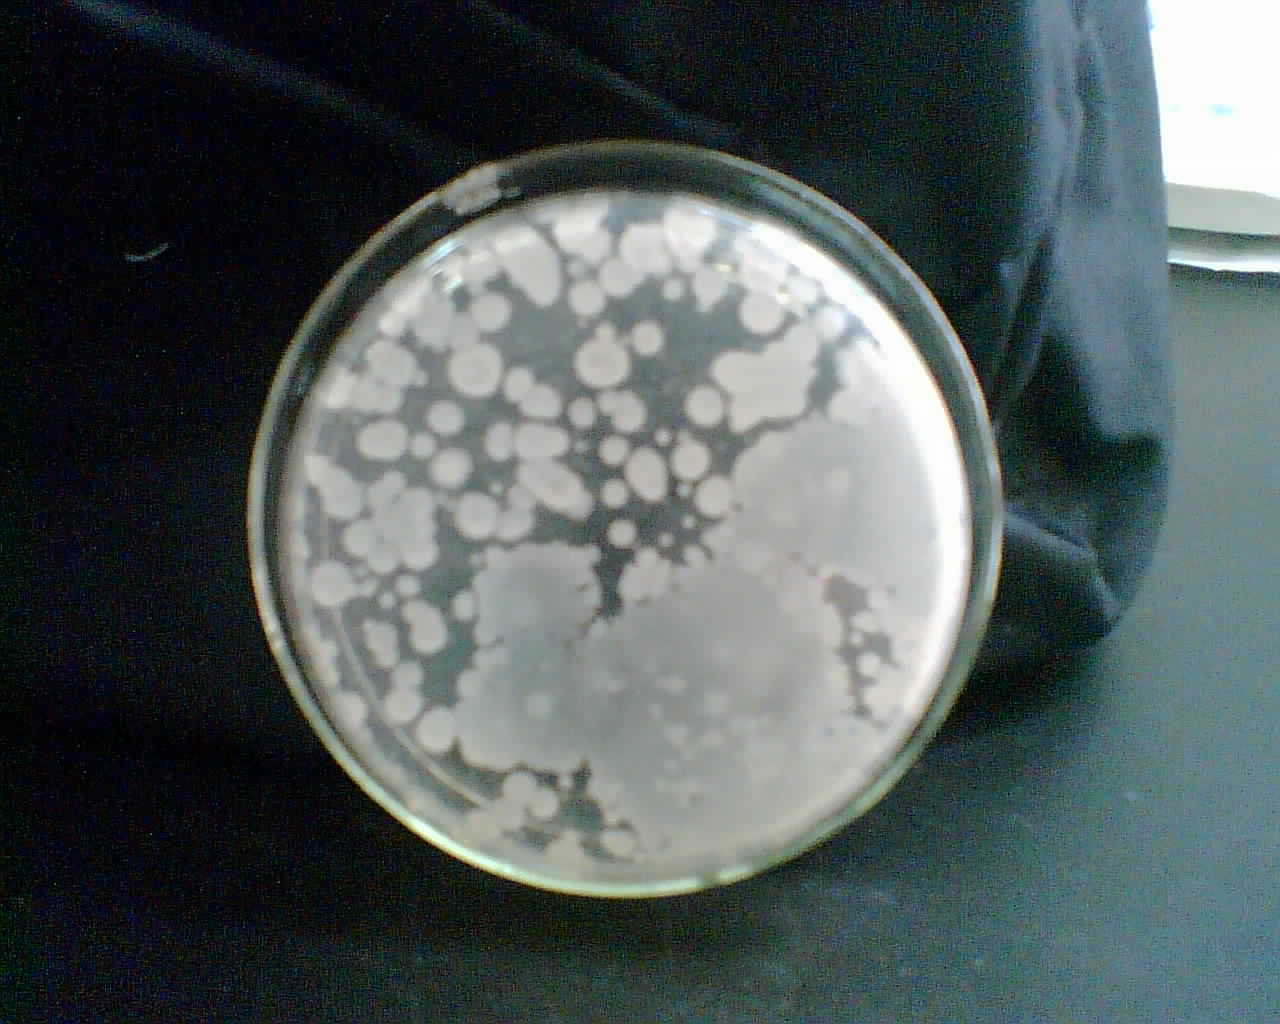
细菌菌落

细菌菌落

细菌的菌落特征
图片尺寸875x802
四种颜色的细菌菌落在琼脂平板上,在黑色背景上分离
图片尺寸1106x1100
血平板上不同细菌菌落形态.#创作灵感 #微生物 #实验室 - 抖音
图片尺寸1920x1808
微生物菌落形态特征辨别
图片尺寸1840x3264
在黑色背景下分离的培养皿上的不同细菌菌落照片
图片尺寸317x300
细菌菌落在琼脂平板上分离为黑色
图片尺寸1104x1100
【资源】发现一个细菌菌落精彩照片的新网站
图片尺寸640x512
帮忙签定细菌总数检测出来的菌落是什么菌?
图片尺寸1800x3200
如图 最近细菌总数测定发现菌落变了,这个是什么菌
图片尺寸700x934
培养皿上的细菌菌落
图片尺寸1162x1100
细菌在培养皿上的菌落.霉菌杆菌照片
图片尺寸450x300
所生长出来的细菌菌落总数
图片尺寸573x568
关于孟加拉红培养基上的菌落,这都是霉菌吗
图片尺寸3120x4160
细菌菌落
图片尺寸1151x1100
自动计数培养皿中细菌菌落
图片尺寸1080x810
土壤样品琼脂平板上细菌和霉菌的特性及不同形态菌落背景,供微生物学
图片尺寸1200x800
菌落形态图片.jpg
图片尺寸887x1920
请教怎样根据菌落形态初区分细菌与放线菌
图片尺寸2336x4160
细菌菌落
图片尺寸1280x1024
在tcbs平板上的各种颜色的菌落具体是什么细菌?谢谢
图片尺寸2592x1944